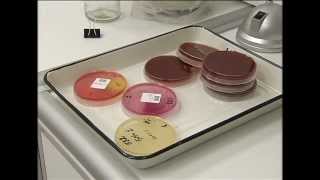

ОНКОЛОГИЯ КАЗАНЬ СИБИРСКИЙ ТРАКТ
Главная Онкология Онкологические центры. Вход в личный кабинет организации. Детские онкологи. Онкологи на дом. Онкологические центры. Платная химиотерапия. Клиника Дружковых.
Казань - ул. Сибирский тракт:
Чтобы увидеть результаты поиска, начните вводить имя врача в поисковой строке. Республиканский клинический онкологический диспансер маммология, онкология, хирургия общая и абдоминальная Россия Татарстан Казань Сибирский тракт, д. 29 - положительные и отрицательные отзывы, рейтинг. Адрес клиники "Онкопрофи": Казань, ул.Сибирский тракт, д Телефоны: () Электронная.
Нас выписали с торокального отд. Диагноз Т2n2М1. Стадия 4, клин. Группа: 4-подлежащие симтоматич лечению, отказав операции. Мотивируя сахарный диабет 2 степени. По месту прописки никакого лечения не назначают. Неужели нет ни какого лечения?
Онкология или Жизнь:
онкологической помощи. Шаг. 4. Направление пациента на консультацию. в поликлинику ГАУЗ «РКОД МЗ РТ» г. Казани или филиалы. ГАУЗ «РКОД МЗ. Республиканский онкологический диспансер (РКОД), Казань: диспансеров Казани (71/), адрес - Казань, Сибирский тракт, д. Казань, ул.Сибирский тракт Регистратура: понедельник-пятница с 7чм. до 18чм. Прием врачей: понедельник-пятница с 8ч.
Всего найдено 9 клиник онкологии. Вы можете записаться на приём в любую из представленных на странице клинику через сервис MedCentr. Online сейчас. Центр челюстно-лицевой хирургии и пародонтологии предлагает спектр услуг в сфере оториноларингологии, эстетической хирургии, челюстно-лицевой хирургии и имплантологии. Очень располагающий к себе и профессиональный врач. Это человек, которому хочется доверять. Он провел хорошую хорошую консультацию, обозначил все мои проблемы и рассказал о их решении.
Республиканский клинический онкологические диспансер. Татарстан. Казань:
Казань, Сибирский тракт, 29 +7 () Медицинское комплексное обслуживание в Казани. Ошибка в описании? Сообщите нам!5/5(1). Адрес: , Казань, Сибирский тракт, д. 29 [смотреть на карте] Оказывая медицинские услуги, врачи должны в первую очередь оставаться людьми. Казань, Сибирский тракт, 14 ( км) Филиал № 1 городской детской поликлиники № 6. Казань, улица Журналистов, 9 ( км) Детская городская больница № 8. Казань.
Справочник Казани Диспансеры онкологические Диспансеры онкологические в Казани В справочнике Казани мы нашли 56 онкологических диспансеров; справочник товаров и услуг в Казани, схемы проезда, рейтинги и фотографии; вы можете оставить свои отзывы об онкологических диспансерах в нашем каталоге организаций. Амбулаторное Реабилитационное отделение Нить Ариандны , просп. Победы, , Казань. Маршала Чуйкова, 54, Казань. Маршала Чуйкова, 54, корп.
Областной онкологический диспансер:
Казань, Сибирский тракт, Отделение паллиативной медицинской помощи. г. Альметьевск, пр. Строителей, Поликлиника №3. Республиканский клинический онкологический диспансер: адреса со входами на карте, Сибирский тракт, , Советский район, Казань. Вход. Айболит, семейный медицинский центр. Сибирский тракт, 29 к АСибирский тракт, 29 к3. , Советский район, Казань. Вход. Национальный архив.
Научно-практический журнал для практикующих врачей и научных работников. Казань, Сибирский тракт, д. У вас должен быть включен JavaScript для просмотра. Современную онкологию трудно представить без такого метода, как лекарственная терапия. Однако именно этот вариант лечения имеет невероятно бурный темп развития и космический уровень достижений.
Пожар 29 января Казань Сибирский Тракт 34(3)
Онкология. Рак. Что такое раковая опухоль? Это жизненно важно знать каждому! Ч.1
Главный онколог Татарстана в 33 года